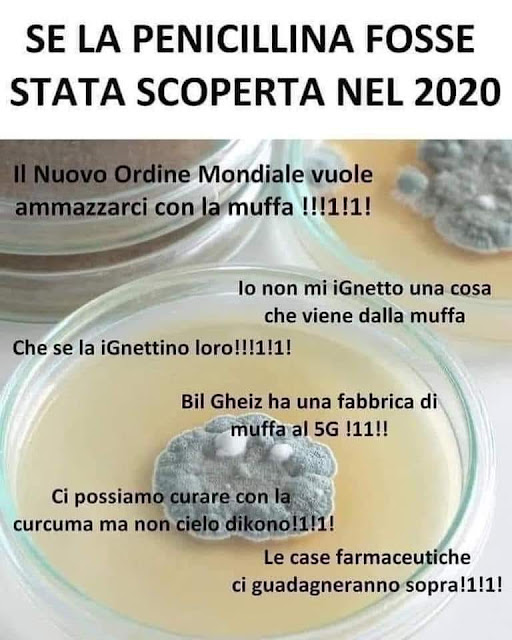

I bambini nascevano ancora in casa, in tanti angoli del Belpaese, nell'immediato Secondo Dopoguerra.
Nelle vecchie case, con piccole finestre, la calcina sui muri, senz'acqua corrente (c'erano ancora i pozzi e le fontane), l'igiene era quel che era: e poteva capitare che la madre andasse incontro alla temuta febbre puerperale, un'infezione batterica al tempo fatale in molti casi.
Il dottor Semmelweis insegnò ai futuri medici l'importanza del lavaggio delle mani per prevenire questa condizione che, a metà Ottocento (e anche dopo), pure in un grande ospedale, poteva suonare come una campana a morto. La triste fine che fece Semmelweis l'ho richiamata QUI.
Forse anche certe levatrici di paese avrebbero fatto bene ad imparare l'importanza del lavaggio delle mani, che qualche volta poteva non risultar eseguito in modo scrupoloso e accurato.
Poteva così capitare che la puerpera incorresse nella febbre: magari abitando in un paesino vicino alla città poteva essere ricoverata in ospedale, dove i medici non avevano molti strumenti per contrastare le infezioni - almeno non fino all'introduzione dei sulfamidici e - successivamente - degli antibiotici.
Ho ricordato QUI, nella pubblicazione, stesa con il professor Barbazza e data alle stampe lo scorso anno, che la penicillina fu introdotta in Italia a Napoli, nel 1944, ed usata per trattare la sifilide, che si diffondeva tra i soldati e le prostitute (qualcuno ricorda "La pelle" di Curzio Malaparte?).
Negli anni a venire, la penicillina non sarebbe stata ancora disponibile dovunque: forse si trovava nelle farmacie delle grandi cliniche universitarie, ma poteva mancare in quelle dei piccoli ospedali di provincia.
Lo stesso dicasi per altri farmaci, allora nuovi: ricordavo tempo fa i miei nonni paterni, malati di tubercolosi. Mia nonna, all'ospedale civile di Belluno, fu trattata con il PAS; mio nonno, ricoverato in sanatorio prima a Gorizia e poi a Como, fu tra i primi in Italia a beneficiare del trattamento con la streptomicina - scoperta da Waksman e collaboratori appena da qualche anno.
Così una neo-mamma, che ha appena partorito in casa, incorsa nella famigerata febbre puerperale e ricoverata nel piccolo ospedale di provincia, poteva non ottenere le cure necessarie a superare la malattia - a meno che non avesse una fortuna tale per cui il marito, o qualche buon uomo, fosse automunito (cosa rara quanto la penicillina!) e provvedesse a correre lungo le strade bianche per riuscire a procurare (a sue spese!) in tempo il farmaco necessario, recandosi presso una grande clinica o presso un ospedale militare o, ancora meglio, presso una base americana.
Una serie di concomitanze tanto fortunate quanto improbabili avrebbero permesso così alla madre di sopravvivere e di crescere il suo bambino.
Nello scrivere questo post, mi sono ispirato al racconto di una persona che un dramma simile lo ha vissuto sulla propria pelle esattamente settant'anni fa, nella parte del bambino venuto al mondo in una vecchia casa di un paesino di provincia che sarebbe potuto crescere senza mamma se la Medicina non avesse avuto a disposizione, grazie alla Chimica, un'arma potentissima per sconfiggere le infezioni batteriche: la penicillina. E qui vorrei offrire alcune considerazioni.
Settant'anni fa, nella miseria e nella disperazione, un uomo parte di notte, facendo chilometri e chilometri, alla ricerca di un farmaco che deve pagare di tasca sua per salvare la vita di una donna che ha da poco partorito un bambino.
Oggi abbiamo strumenti, come i vaccini, gratuiti e comodamente disponibili vicino a casa, per evitare le infezioni. Li rifiutiamo e vogliamo i dati per metterne in discussione la validità.
A proposito di dati, immaginate cosa sarebbe successo se i protagonisti della nostra storia si fossero schifati perché il farmaco salvavita era (ed è tuttora) tratto da colture selezionate di una muffa, rifiutandolo; o se avessero voluto conoscere i dettagli della produzione industriale e commentare (a quale titolo) il ruolo dell'acido fenossiacetico o del solfato di ammonio o di altre sostanze nei vari passaggi della preparazione.
O peggio, se avessero voluto conoscere la struttura della molecola della penicillina per dubitare del magistrale lavoro compiuto dalla grandissima scienziata Dorothy Hodgkin con la diffrattometria ai raggi X, pretendendo di vederne le immagini - una serie di macchie di varie forme e dimensioni, alle quali non avrebbero saputo dare significato a meno che non fossero dei chimici strutturisti.
Mi pare che si perda tempo in sterili polemiche. E intanto si avvicina la stagione fredda.

Nessun commento:
Posta un commento